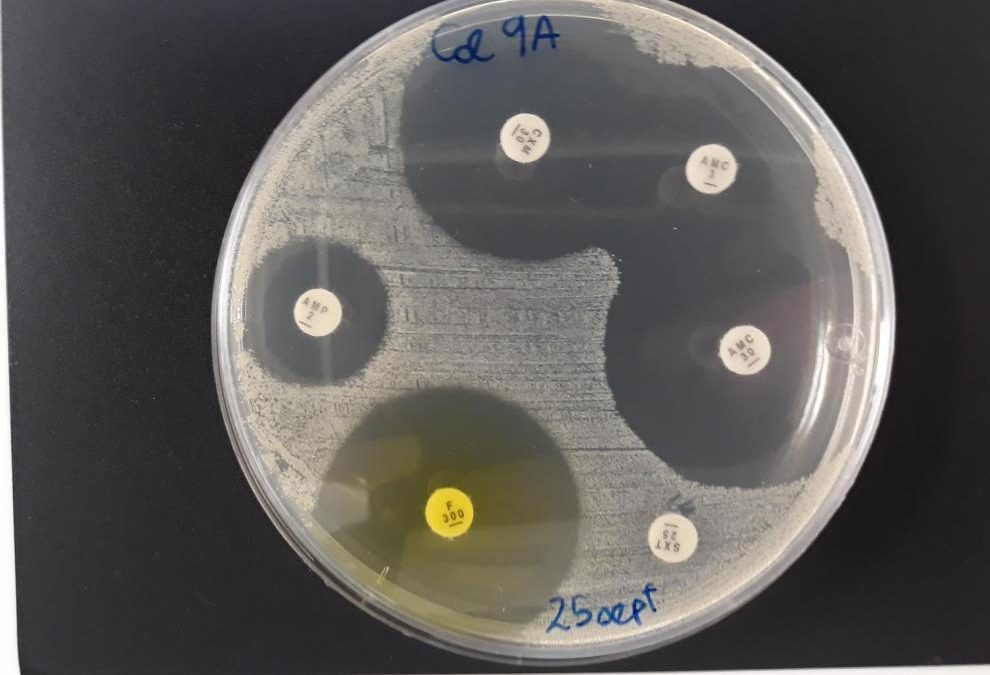

Pandemia de infecciones resistentes a los antibióticos

Potenciar la investigación biomédica, una garantía para el futuro sanitario, económico y social de España
17 mayo, 2021
Naiara recibe su nuevo corazón en un trasplante único en el mundo
18 mayo, 2021Casi no recordamos cómo era un mundo sin antibióticos, donde muchas infecciones bacterianas eran sinónimo de muerte. Pero, casi cien años después del descubrimiento del primer antibiótico, un uso excesivo e inadecuado de estos fármacos está haciendo retroceder su eficacia y cada día son más las bacterias resistentes. Esta es ya hoy una de las amenazas más serias para la salud pública.
Estocolmo, 11 de diciembre de 1945. Ceremonia de entrega de los Premios Nobel. Alexander Fleming inicia emocionado el relato del descubrimiento de la penicilina, sus extraordinarias propiedades y su potencial terapéutico. La penicilina es capaz de eliminar las bacterias que causan muchas infecciones comunes entre las personas, sin presentar toxicidad ni causar daño a las células de nuestro propio cuerpo. Aunque su descubrimiento original, en 1929, apenas llamó la atención de la comunidad científica, años más tarde, Ernst Chain y Howard Florey (con los que comparte el galardón) retomaron los trabajos con esta molécula maravillosa hasta conseguir su utilización como medicamento, lo que cambiaría para siempre la historia de la medicina.
Un gran impacto
El Centro Europeo para la Prevención y Control de Enfermedades, junto con la OCDE (Organización para la Cooperación y el Desarrollo Económico), han estimado el impacto de la resistencia a antibióticos en Europa. Cada año se producen 670.000 casos de infecciones causadas por bacterias resistentes, lo que ocasiona 33.000 fallecimientos, de los que aproximadamente unos 3.000 se producen en España. Se estima que los costes sanitarios, laborales y sociales (hospitalización, medicamentos, bajas por enfermedad,…) ascienden a 1.100 millones de euros en el conjunto de Europa. Si no se consigue frenar esta ‘pandemia de infecciones resistentes’, las predicciones auguran que en el año 2050 habrá 390.000 muertos en Europa y unos 40.000 en España. Estos estudios apuntan a un mayor impacto en los países del sur y del este de Europa. ¿Puede haber una solución? Para tratar de frenar el impacto de la resistencia a antibióticos, la OCDE y el Centro Europeo para la Prevención y Control de Enfermedades han calculado que bastaría con invertir un euro y medio por habitante y año en acciones como campañas sobre el uso correcto de antibióticos, retrasar su prescripción de antibióticos y la mejora de la higiene de manos. De esta forma, se estima que el número de muertes anuales por infecciones resistentes en la UE podría reducirse desde las 33.000 actuales a poco más de 6.000.
Cuando una bacteria se ha hecho resistente a los antibióticos por alguno de estos mecanismos, sus descendientes (las bacterias ‘hijas’) también lo serán. Además, algunas bacterias que poseen enzimas para destruir o alterar los antibióticos, pueden transferir estas enzimas a otras bacterias, incluso de especies distintas, con lo que la capacidad para resistir a los antibióticos se propaga entre las poblaciones bacterianas. Estos mecanismos contribuyen a aumentar la incidencia de infecciones resistentes a antibióticos, y consecuentemente, dificultan su curación porque para tratar una infección causada por una bacteria resistente, deben utilizarse otros antibióticos que con frecuencia son menos activos o más tóxicos para el paciente.